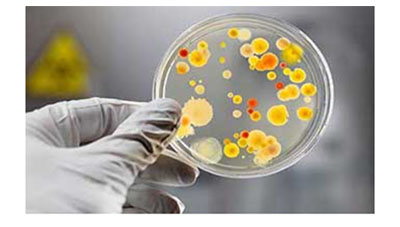

Quando procurar um infectologista?
Muitas infecções são tratadas com outros especialistas, mas em algumas situações, a experiência do profissional infectologista tem impacto direto no sucesso do tratamento:
Febre de Origem Indeterminada:febre prolongada por mais de 15 dias sem causa determinada por exames laboratoriais e de imagem; uma das síndromes mais difíceis de chegar ao diagnóstico. Como na grande maioria das vezes resulta em doenças infecciosas, quem tem maior experiência é o infectologista.
Hepatites Virais- Hepatites crônicas B e C, diagnóstico acompanhamento e tratamento.
HIV, SIFILIS ; diagnóstico ou aconselhamento no sentido de se evitar estas doenças sexualmente transmissíveis, além de acompanhamento de exposições de risco para HIV orientando ate o final do período da janela imunológica.
Doenças mono-like; Síndromes virais agudas com quadro clínico semelhante conhecido como Síndrome da Mononucleose: febre, lesões de pele, gânglios aumentados, fadiga, dor de garganta, mal estar. Engloba doenças como Rubéola, Toxoplasmose, Citomegalovirose, Mononucleose Infecciosa, Sífilis, e infecção aguda pelo HIV.
Doenças causadas pelo Herpes Vírus: Varicela (catapora), Herpes labial, Herpes genital, e Herpes Zoster (cobreiro)
Orientações quanto ao uso de antibióticos em infecções ósseas, cardíacas, respiratórias, de pele, hospitalares ou da comunidade.
Tuberculose pulmonar e extra-pulmonar (fora dos pulmões).
Controle de infecções hospitalares após a alta: o paciente deve levar todos os exames que colaboraram para o diagnóstico, assim como relato dos antibióticos usados ou receita em uso.